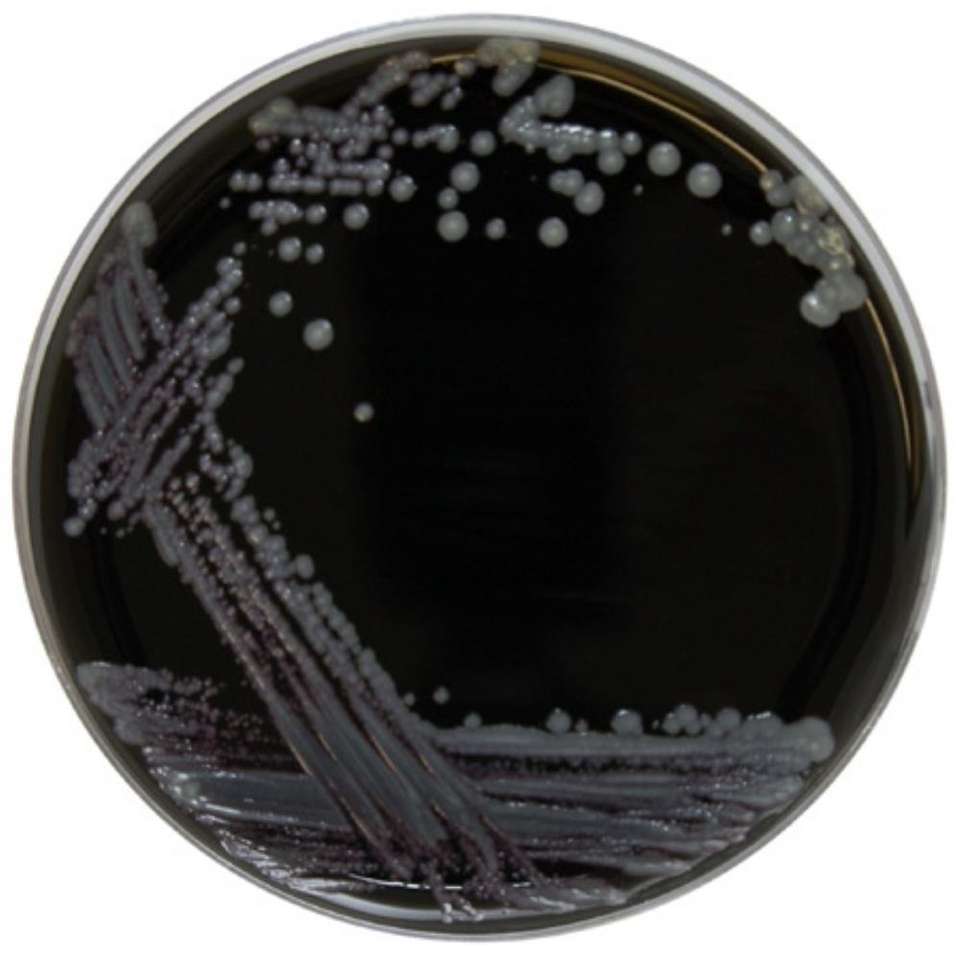

EO Labs 10X90mm Fournitures de laboratoire Agar + Céphalexine Plaques de charbon de bois
Note de la boutique :4.6
(1 avis)
Caractéristiques du produit
Emballage et livraison
vente Unités
Article unique
Description des produits par le fournisseur
Quantité minimale : 1 pièce
10,45 €
Quantité
Expédition
Frais de livraison et date de livraison à négocier. Contactez le fournisseur dès maintenant pour plus d’informations.
Sous-total de l'article
0,00 €
Montant des frais de port
À négocier
Sous-total
0,00 €
Protection des commandes Alibaba.com
Paiements sécurisés
Chaque paiement que vous effectuez sur Alibaba.com est sécurisé par un cryptage SSL strict et des protocoles de protection des données PCI DSS.
Protection de remboursement
Demandez un remboursement si votre commande n'est pas expédiée, est introuvable ou arrive avec des problèmes liés au produit









